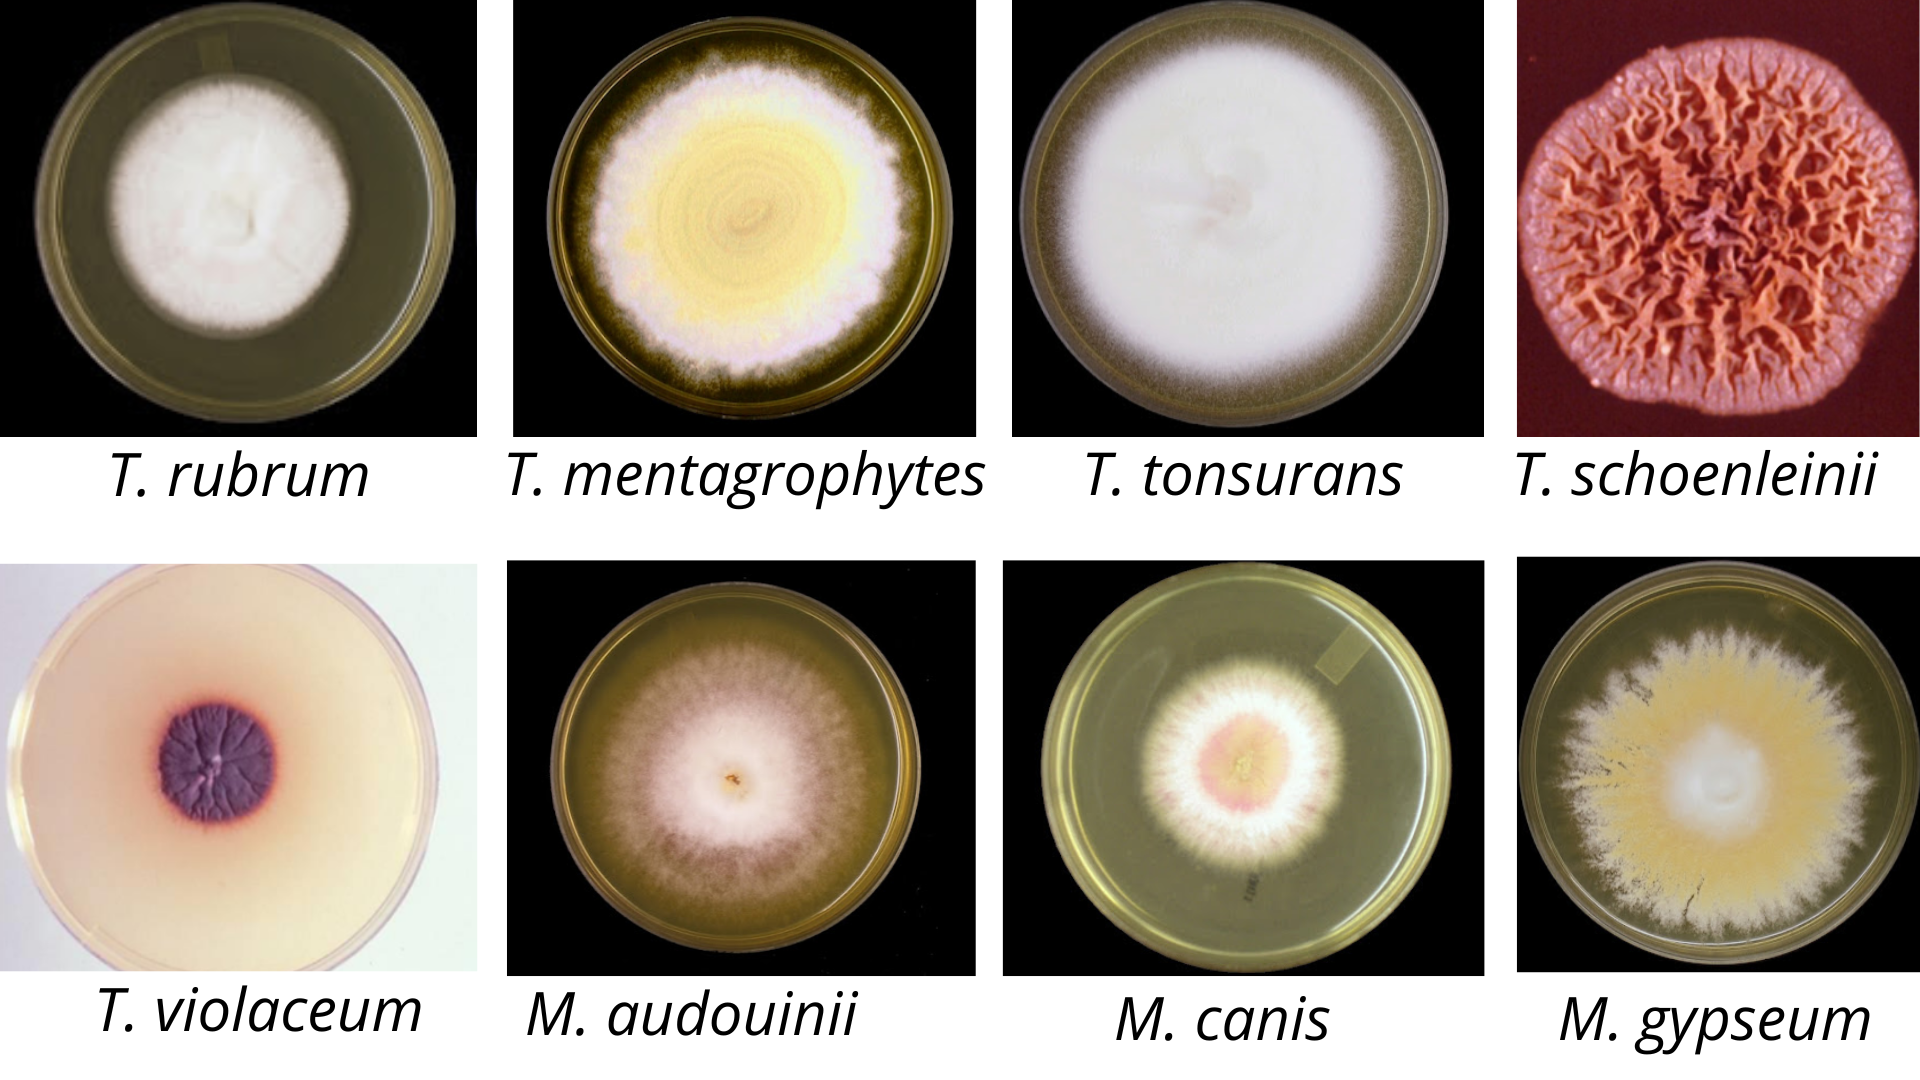
Colony morphology of Trichophyton and Microsporum - Colony ofTrichophytonandMicrosporum

Dermatophytes are keratinophilic and keratinolytic fungi. They canaffect all keratinized body areas (hair, skin, and nails) and cause cutaneous mycosis (dermatophyte infection or dermatophytosis).
Dermatophytosis spreads by direct or indirect contact with the infected animal or humans. Indirect transfer can occur from the swimming pool floor, showers, brushes, etc. Direct transfer can occur by the viable fungus in the keratin fragments of skin, hair, and nails. The three clinically significant dermatophytes are Trichophyton, Microsporum, and Epidermatophyton.
- The genus Trichophytonis capable of invading the hair, skin, and nails.
- The genus Epidermophyton involves the skin and nails only (not hairs).
- The genus Microsporuminvolves only the hair and the skin**(not nails).**
Mnemonics to remember which dermatophyte does not affect what:Trichophyton: Infects all three(so Tri)â i.e. Skin, Nail and HairEpidermophyton does not affectHair(REMEMBER âEâ is close to âHâ alphabetically and it does not infect near ones)Microsporum does not affectNailsas âMâ is close to âNâ(similar scenario of not infecting neighbors)
Dermatophytes cause Tinea or ringworm infections. The common symptoms of dermatophytes are irritation, erythema (redness of the skin), edema (swelling), and vesiculation (formation of the vesicle or cyst). In the Tinea pedis, infection is mainly confined to the toeâs clefts. An infected nail gets discolored, thickened, raised, and friable (easily reduced to powder). Most nail infections are due to theT. rubrum.
Classification of Dermatophytes
Dermatophytes are classified into three genera based on the conidiaâs morphology and formation: Trichophyton(T),Microsporum(M), andEpidermatophyton(E). Conidia is the structure of asexual reproduction. Many dermatophyte species produce two types of asexual spores: multi-celled macroconidia and single-celled microconidia (arthroconidia).

Dermatophytes are classified into three groups based on their habitat: soil (geophilic species), animals (zoophilic species), and man ( anthropophilic species).
- Anthropophilic organisms: T. rubrum, T.interdigitale, T. tonsurans, T. violaceum,M.audouinii,M. ferrugineum.
- Zoophilic organisms: M. canis ( originating from cats and dogs), M. nanum (originating from pigs), T.equinum (originating from horses), T. verrucosum( originating from cattle)
- Geophilic organisms: M. gypseum, M. fulvum
Pathogenesis of Dermatophytes
Virulence factors of dermatophytes are arthroconidium (asexual spores), enzymes (keratinase, protease, lipase), and mannanof the fungal cell wall.
Adherence
Arthroconidium (asexual spores produced by dermatophytes) adheres to the surface of the tissue. Trichophyton rubrum adheres to the epithelial cells by the carbohydrate-specific adhesions, which are expressed on the surface of the spores. Fibrillar projections have been observed in the T. mentagrophytes during the adherence phase. At the skin surface, long and sparse (thin) fibrils connect fungal arthroconidia to keratinocytes.
The arthroconidium then germinates into hypha, and hypha enters into the stratum corneum (the outermost layer of the epidermis). In the pathogenesis of dermatophytoses, the initial interaction between the arthroconidia and the stratum corneum occurs 3-4 hours after contact.
Penetration
After the adherence, dermatophytes need to obtain the nutrients for their survival. To use the nutrients, the proteins, starch, cellulose, and lipids are degraded into smaller compounds. Dermatophytes then secrete various enzymes like proteases, lipases, elastases, collagenases, phosphatases, and esterases to degrade the complex compounds into simple ones. Keratinases degrade the keratin present in the host tissues into oligopeptides or amino acids. Proteolytic enzymes degrade the proteins of the skin. It helps in the penetration of the stratum corneum.
Development of host response
Dermatophytes have mannan, which suppresses the inflammatory response. It also inhibits the proliferation of the keratinocytes, which allows for establishing the persistent infection.
Clinical features
Dermatophytes cause dermatophytosis, which is also known as the tinea or ringworm. The clinical presentation of the infection depends on the species, strain of fungus, size of the inoculum, anatomical site, and immune status of the host.

1. Tinea capitis
Tinea capitis is the infection of the shaft of scalp hairs caused by the fungus Trichophytonspp. and Microsporum canis. The infection starts on the scalp, where the dermatophytes grow down the keratinized wall of the hair follicles. The infected hair appears dull and grey. T. capitis presents two clinical forms: inflammatory and non-inflammatory.
- Inflammatory: Kerion, favus, and agminate folliculitis
- Non-inflammatory: Black dot, seborrheic dermatitis-like, and grey patch
Kerion
It is the severe form of dermatophytosis which causes deep, suppurative lesions on the scalp. Follicles may be seen with the discharging pus. It is usually caused by the T. verrucosum and T. mentagrophytes, zoophilic dermatophytes. In children, one of the common clinical forms of tinea infection is kerion celsi.
Favus
The word favus is derived from the Latin word favus which means the honeycomb-like appearance. Favus is caused by T. schoenleinii, and it forms the cup-like crusts around the infected follicles. The fungal growth occurs within and around the hair follicle, which produces waxy, honeycomb-like crusts on the scalp. It may lead to alopecia (loss of hair) and scarring.
Black dotBlack dot is usually caused by the T. tonsurans and T. violaceum. It attacks the hair shaft by endothrix type invasion with the abundant sporulation inside the hair and breakage of the hair near the surface of the scalp. It results in a black-dot appearance within an area of smooth scalp surface.
2. Tinea corporis
Tinea corporis is caused by Trichophyton rubrum. It is the infection of the bodyâs glabrous (non-hairy) skin and is caused by tinea glabrosa or tinea glabrata circinata. It is characterized by erythematous scaly lesions and annular, sharply marginated plaques with a raised border that may be single, multiple, or confluent.
3. Tinea pedis (Athleteâs foot)
Tinea pedis is also known as the athleteâs foot because it is seen in individuals who wear shoes for a long period. The warmth and the moisture facilitate the establishment of the fungus.
It causes the infection of the foot, toes, and interdigital web spaces. In the toe webs, scaling, fissuring, maceration, and erythema are associated with the itching and burning sensation. The small vesicles rupture and the thin fluid is discharged. Then there are the chances of secondary infection as the skin will become macerated and peel. Lymphangitis and lymphadenitis will occur in the case of secondary infection.
Further, it will cause the Moccasin or Sandal ringworm. In this condition, the infection extends from the sole to the side of the foot. It is also known as the one-hand-two feet syndrome because it causes infection in the one-hand and two feet of the patient. In the chronic infection, the sole becomes hyperkeratotic, often covered by fine scales. The causative agent of the athleteâs foot is Trichophyton rubrum, Trichophyton mentagrophytes, and Epidermatophyton floccosum. Tinea pedis is divided into four types: interdigital, hyperkeratotic, ulcerative, and vesicular.
4. Tinea barbae
Tinea barbae is the ringworm infection of the beard and mustache area of the face. It is also called barberâs itch or tinea sycosis. In this condition, erythematous patches can be seen on the face, which shows scaling, fragile, lusterless hairs. It has got a tendency to develop folliculitis. The main causative agent of the Tinea barbae are Trichophyton verruosum,Trichophyton mentagrophytes. Microsporum canis and T. rubrum are occasionally found in it.
5. Tinea manuum
Tinea manum is the palmâs ringworm infection caused by T. rubrum, T. mentagrophytes, and Epidermatophyton floccosum.
6. Tinea unguium
Tinea unguium is the dermatophyte infection of the nail, caused by T. rubrum, T. mentagrophytes, and Epidermatophyton floccosum**.**
Causative agents
Tinea is caused by the dermatophytes, which include the fungus of the genusTrichophyton, Microsporum, and Epidermatophyton.
Trichophytonspp
Trichophyton grows only within dead keratinized tissue. It infects skin, hair, and nail. It produces the keratinolytic protease enzyme, which facilitates the entry of the fungus into the living cells. Â The important trichophyton species are Trichophyton rubrum, T. mentagrophytes, T. tonsurans, T. schoneleinii, T. violaceum, T. verrucosum. The Trichophyton rubrum does not perforate the hair in vitro and does not produce urease enzyme, whereas T. mentagrophytes perforates the hair in vitro and produce urease enzyme.
Epidermatophytonspp
Epidermatophyton floccosum is the causative agent of Tinea cruris and Tinea pedis. It doesnât invade the hair and grows in the epidermis, i.e., skin and nails. It doesnât produce the microconidia, whereas another dermatophyte, Trichophyton, and Microsporum produce both the microconidia and macroconidia. Epidermatophyton produces only macroconidia.

Microsporumspp
Microsporum infects the skin and hair but not the nail. The three species of Microsporum that is mostly pathogenic are Microsporum audouinii, M canis, and M gypseum. Rice grain test is the specific test for Microsporum spp. Microsporumspp. primarily grow on the surface of hair shafts (ectothrix), whereas Trichophyton spp. may grow inside the hair shafts (endothrix) and makes the hair fragile and breaking it or at the surface of the hair follicles.
Laboratory diagnosis of Dermatophytes
Clinical observation and laboratory investigation play a crucial role in diagnosing fungal infection. The sample of choice are the skin, nail, and plucked hairs of short length from the involved sites**.**
1. Collection of samples
Hair, nail, and skin samples are taken in a folded square of black paper or the card. When paper is used, it helps to dry out the specimens preventing them from bacterial contamination. It helps to store the fungus for 12 months without losing its viability.
Hairs
For the hair sample collection, instead of cutting, hair is plucked from the edge of the lesion**.**
Skin
For the skin sample collection, it needs to be washed well and then scraped from the margin of the lesion onto the folded black paper.
Nail
Nails scrapping is taken from the nail bed or infected areas after discarding the outer layers.
Scales
It includes the hair stubs, the contents of plugged follicles, and skin scales.
Hairbrush sampling
Use the sterile plastic brush and brush it on the scalp. Then inoculate the plastic brush by pressing it in the agar suitable culture media.
2. Woodâs Lamp Examination
It is a device used to diagnose and manage superficial cutaneous fungal infections. It is used for the examination of the scalp and ringworm infection. Most of the infected hair fluorescence when exposed to ultraviolet light. Microsporum audouinii and Microsporum canis fluorescens bright yellow-green, whereas Microsporum gypseum does not fluorescens. Non-fluorescent fungi like T. tonsurans and T. verrucosumare difficult to detect. In Woodâs lamp, positive fluorescence occurs in infected hairs due to using a chemical substance called pteridine. Sometimes false positives may occur if other substances also consist of pteridine. An error may occur when the ointments containing petroleum, jelly, scales, serum, exudates, lint, and dried soaps fluorescens bluish or purple.
| Microorganisms | Fluorescence Color |
|---|---|
| Microsporum audouinii | Bright-green |
| Microsporum canis | Bright-green |
| Microsporum ferrugineum | Blue-green |
| Microsporum distortum | Blue-green |
| Microsporum gypseum | Dull-yellow |
| Trichophyton schoenleinii | Dull-green |
| Malassezia furfur | Golden-yellow |
| Corynebacterium minutissimum | Coral-red |
3. Direct microscopy
Place the specimen on a clean, grease-free slide and add 10-20% KOH. Cover it with the cover slip and examine it after 20 minutes. In the skin or nails, branching arthrospores are seen. In the hair, Trichophyton spp. forms parallel rows of spores outside (ectothrix) or inside (endothrix) of the hair shaft. T. tonsuransand T. violaceumshow the endothrix type of hair invasion. T. mentagrophytesshow ectothrix type of hair invasion. Hairs infected with the T. schoneleiniishow hyphae and air spaces within the shaft.
Read more from this link: KOH wet mount
4. Fungal Culture
The suitable media for the fungal culture is Potato Dextrose Agar (PDA) or Sabouraudâs dextrose agar(SDA) used for culture. Incorporating antibiotics like gentamicin and chloramphenicol in Sabouraudâs media will inhibit the overgrowth of bacteria. Incorporating the cycloheximide will inhibit the overgrowth of the rapidly growing saprophytic fungi. Sabouraud peptone-glucose agar (Emmonsâ modification) mixed with cycloheximide and chloramphenicol is commonly used. Its commercial names are Mycobiotic and Mycosel agars. Inoculation is done at 25-30â for 1-3 weeks. The fungi are identified based on colonial appearance, color, pigment production, and microscopic observation. For the microscopic observation, lactophenol cotton blue staining is performed.
Morphological Characteristics of Dermatophytes
| Dermatophytes | Colony morphology | Microscopic observation |
|---|---|---|
| Trichophyton rubrum | Velvety, red pigment on reverse | Tear-drop, microconidia, a few long, pencil-shaped macroconidia |
| Trichophyton mentagrophytes | White to tan, cottony or powdery, pigment variable | Clusters of microconidia cigar-shaped macroconidia with terminal rat-tail filaments |
| Trichophyton tonsurans | Powdery to cream or yellow with central furrows | Abundant microconidia, thick-walled, irregular macroconidia |
| Trichophyton schoenleinii | Smooth, waxy, brownish | Hyphal swellings, chlamydopsores, favic chandelier |
| Trichophyton violaceum | Very slow growing, waxy, violet to purple pigment | Distorted hyphae, conidia rare |
| Microsporum audouinii | Velvety, brownish, slow growing | Thick-walled chlamydospores, conidia rare and irregular |
| Microsporum canis | Cottony, orange pigment on reverse | Abundant, thick-walled spindle-shaped macroconidia with up to 15 septa |
| Microsporum gypseum | Powdery, buff-colored Yellowish-green | Abundant, thin-walled macroconidia with 4-6 septa |
| Epidermatphyto floccosum | Slow growing, powdery, greenish-brown | Club-shaped macroconidia in clusters |

5. Rice Grain Test

Rice grain test differentiates theM. audouinnifrom the otherMicrosporum species. M. audouiniidoesnât grow in the presence of rice grain. Sterile non-fortified rice is inoculated lightly with the hyphae of the test isolate. Then after 10 days of incubation at room temperature, the medium is observed for growth. M. canis and other dermatophytes grow well and usually form many conidia, but M. audouiniidoes not grow.
6. Dermatophyte Test Medium (DTM)
Dermatophyte Test Medium is used for the presumptive identification of dermatophytes from the other fungal or bacterial contaminants. It helps to distinguish whether the cutaneous lesion is caused by dermatophytes, other fungi, or bacteria. When incubated at 25â, the dermatophytes turn the medium red, whereas bacteria and other fungi cannot change it. To avoid the false positive result caused by DTM, dermatophyte identification medium (DIM) is also used.
7. Hair Perforation Test

Hair Perforation is the differential test to differentiate the morphologically similar fungal species. It is used to distinguish the Trichophyton rubrum and Trichophyton mentagrophytes. Trichophyton rubrum causes the surface erosion of the hair shaft, whereas Trichophyton mentagrophytescause wedge-shaped perforation. The hair perforation test also differentiates the Microsporum canisand Microsporum equinum. Microsporum canis perforates the hair, but the Microsporum equinum does not perforate.
8. Urea hydrolysis test
Incubation is done for 2-3 days on Christensenâs Urea Agar. It is used to differentiate between Trichophyton rubrum and *Trichophyton mentagrophytes.*When the urea is hydrolyzed, the media turns deep red. T. mentagrophytesshows positive results as it produces urease enzyme within 2-4 days, whereas T. rubrumshows negative results.
Treatment
For most skin infections, topical therapy is satisfactory. Oral antifungals are required to treat nail and scalp infections and severe or extensive skin infections. Topical agents include azole compounds, terbinafine, amorolfine, and ciclopirox olamine. Oral griseofulvin is beneficial for scalp, skin, and fingernail infections. Terbinafine and itraconazole have largely replaced griseofulvin for treating nail infections because of their much better cure rates and shorter treatment periods.
Prevention and Control
- Routine inspection of the scalps should be done, and avoid sharing of combs and brushes.
- Barbershop instruments ( combs, brushes, and scissors) must be disinfected.
- Infected clothing, towels, and bedding, these items need to be disinfected after use because there is a chance of transmission of theTinea corporis and Tinea cruris.
- Prevention of the tinea pedis can be enhanced by using good foot hygiene.
References
- Brasch, J., MĂźller, S., & Gräser, Y. (2015). Unusual strains of Microsporum audouinii causing tinea in Europe. Mycoses, 58(10), 573â577. https://doi.org/10.1111/myc.12358
- GREGORY., P. H. (1935). the Dermatophytes. Biological Reviews, 10(2), 208â233. https://doi.org/10.1111/j.1469-185X.1935.tb00483.x
- Su, H., Packeu, A., Ahmed, S. A., Al-Hatmi, A. M. S., Blechert, O., Ilkit, M., Hagen, F., Gräser, Y., Liu, W., Deng, S., Hendrickx, M., Xu, J., Zhu, M., & De Hoog, S. (2019). Species distinction in the Trichophyton rubrum complex. In Journal of Clinical Microbiology (Vol. 57, Issue 9). https://doi.org/10.1128/JCM.00352-19
- Chander, J. (2018). Textbook of Medical Mycology (Fourth edition). Jaypee Brothers Medical Publishers Ltd.
- profile, V. (2022). Trichophyton rubrum. Thunderhouse4-yuri.blogspot.com. Retrieved 21 August 2022, from http://thunderhouse4-yuri.blogspot.com/2012/02/trichophyton-rubrum.html.